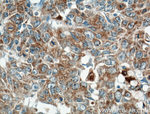
ARNTL Antibody in Immunohistochemistry (Paraffin) (IHC (P))

Search
Proteintech
ARNTL Polyclonal Antibody
{{$productOrderCtrl.translations['antibody.pdp.commerceCard.promotion.promotions']}}
{{$productOrderCtrl.translations['antibody.pdp.commerceCard.promotion.viewpromo']}}
{{$productOrderCtrl.translations['antibody.pdp.commerceCard.promotion.promocode']}}: {{promo.promoCode}} {{promo.promoTitle}} {{promo.promoDescription}}. {{$productOrderCtrl.translations['antibody.pdp.commerceCard.promotion.learnmore']}}
产品信息
14268-1-AP
种属反应
已发表种属
宿主/亚型
分类
类型
抗原
偶联物
形式
浓度
规格
纯化类型
保存液
内含物
保存条件
运输条件
产品详细信息
Immunogen sequence: MADQRMDIS STISDFMSPG PTDLLSSSLG TSGVDCNRKR KGSSTDYQES MDTDKDDPHG RLEYTEHQGR IKNAREAHSQ IEKRRRDKMN SFIDELASLV PTCNAMSRKL DKLTVLRMAV QHMKTLRGAT NPYTEANYKP TFLSDDELKH LILRAADGFL FVVGCDRGKI LFVSESVFKI LNYSQNDLIG QSLFDYLHPK DIAKVKEQLS SSDTAPRERL IDAKTGLPVK TDITPGPSRL CSGARRSFFC RMKCNRPSVK VEDKDFPSTC SKKKDRKSFC TIHSTGYLKS WPPTKMGLDE DNEP (1-303 aa encoded by BC041129)
靶标信息
The protein encoded by this gene is a basic helix-loop-helix protein that forms a heterodimer with CLOCK. This complex binds an E-box upstream of the PER1 gene, activating this gene and possibly other circadian rhythym-associated genes. Three transcript variants encoding two different isoforms have been found for this gene.
仅用于科研。不用于诊断过程。未经明确授权不得转售。
生物信息学
蛋白别名: ARNT-like protein 1, brain and muscle; Arnt3; aryl hydrocarbon receptor nuclear translocator like; Aryl hydrocarbon receptor nuclear translocator-like protein 1; Basic helix-loop-helix ARNT-like protein 1; basic helix-loop-helix family member e5; basic-helix-loop-helix-PAS orphan MOP3; Basic-helix-loop-helix-PAS protein MOP3; bHLH-PAS protein JAP3; bHLHe5; Brain and muscle ARNT-like 1; CG8727 PA; Class E basic helix-loop-helix protein 5; cycle; Member of PAS protein 3; member of PAS superfamily 3; MGC47515; mutant basic helix-loop-helix ARNT-like protein 1; PAS domain containing 3; PAS domain-containing protein 3; testis tissue sperm-binding protein Li 50e; Tic; unnamed protein product
基因别名: Arnt3; ARNTL; ARNTL1; BHLHE5; BMAL1; BMAL1b; bmal1b'; BMAL1c; JAP3; MOP3; PASD3; TIC
UniProt ID: (Rat) Q9EPW1, (Mouse) Q9WTL8, (Human) O00327
Entrez Gene ID: (Rat) 29657, (Mouse) 11865, (Human) 406